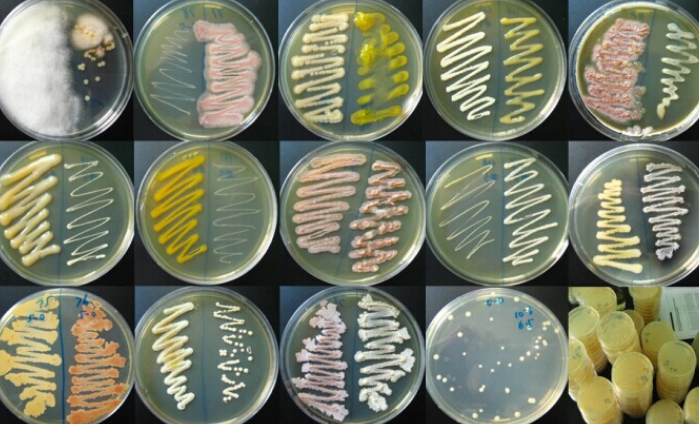

微生物菌種活化方式介紹
微生物菌種是微生物學研究和應用中的基本單元,包括細菌、真菌、放線菌、病毒等。它們在醫學、農業、工業和環境保護等領域具有廣泛的應用。微生物菌種的保存和管理對于確保其遺傳穩定性和生物學特性至關重要,通常通過低溫、干燥、真空冷凍干燥、液氮保存等多種方法進行保藏。在使用菌種時,需要進行活化、傳代、純化等步驟,并定期進行鑒定和確認,以防止污染和遺傳變異。標準菌株和工作菌株的區分也非常重要,前者用于研究和標準,后者用于具體應用。此外,菌種的管理還包括詳細的記錄和操作規程,以確保其安全和有效性。
菌種活化就是將保藏狀態的菌種放入適宜的培養基中培養,逐級擴大培養是為了得到純而壯的培養物,即獲得活力旺盛的、接種數量足夠的培養物。菌種發酵有一般需要2-3代的復壯過程,因為保存時的條件往往和培養時的條件不相同,所以要活化,讓菌種逐漸適應培養環境。
要明白菌種活化的情況就需要了解菌種保藏的方式和方法。目前國際國內常用的菌種保存方法包括:定期移植法、液體石蠟法、沙土管法、真空冷凍干燥法、80℃冰箱凍結法、液氮超低溫凍結法。
對于不同的保存方式活化的方式也不同:
1.定期移植法的菌種復蘇較簡單,直接轉接即可;
2.液體石蠟法保存的菌種在復蘇時,挑取少量菌體轉接在適宜的新鮮培養基上,生長繁殖后,再重新轉接一次;
3.沙土管法保存菌種在復蘇時,在無菌條件下打開沙土管,取部分沙土粒于適宜的斜面培養基上,長出菌落后再轉接一次?;蛉∩惩亮S谶m宜的液體培養基中,增殖培養后再轉接斜面;
4.真空冷凍干燥法保存菌種在復蘇時先用70%酒精棉花擦拭安瓿上部,將安瓿管頂部燒熱,用無菌棉簽沾冷水,在頂部擦一圈,頂部出現裂紋,用挫刀或鑷子頸部輕叩一下,敲下已開裂的安瓿管的頂端,用無菌水或培養液溶解菌塊,使用無菌吸管移入新鮮培養基上,進行適溫培養;
5.-80℃冰箱凍結法保存菌種復蘇時,從冰箱中取出安瓿管或塑料凍存管,應立即放置38℃-40℃水浴中快速復蘇并適當快速搖動。直到內部結冰全部溶解為止,約需50秒-100秒。開啟安瓿管或塑料凍存管,將內容物移至適宜的培養基上進行培養;
6.液氮超低溫凍結法保存菌種復蘇與-80℃冰箱凍結法保存菌種復蘇相似,從液氮罐中取出安瓿管或塑料凍存管,應立即放置在38℃-40℃水浴中快速復蘇并適當搖動。直到內部結冰全部溶解為止,一般約需50秒-100秒。開啟安瓿管或塑料凍存管,將內容物移至適宜的培養基上進行培養。


